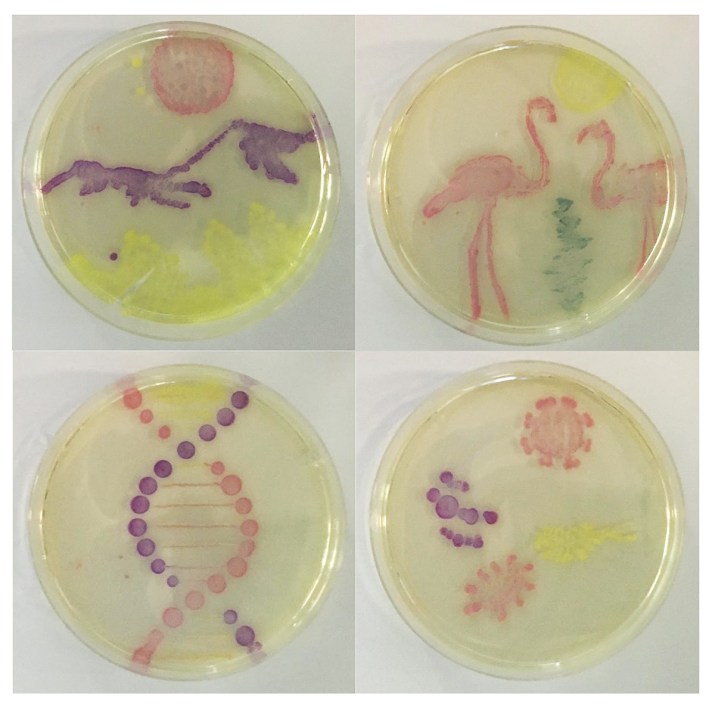
226_media-1

Do you look for ways to involve the holidays in your classroom activities? Valentine’s Day is coming up, and we have a few ideas on how you can add a little holiday flair to your lesson plans! Most of these lessons are STEAM-focused, meaning that they add an arts component to traditional STEM (Science, Technology, Engineering, Mathematics) lessons. By integrating these fields, teachers create experiences that allow students to engage with problem-solving, collaboration, and the creative process in a way that can encourage inquiry and critical thinking in the real world.
Pipetting By Numbers: STEAM Pipetting Practice
Help your students master the fundamental biotechnology technique of micropipetting while creating a colorful, science-themed classroom poster. After completing the poster, students can create their own Valentine’s Day themed works of art.
Living Art: Adding STEAM to Transformations
After performing a transformation experiment (we recommend 222, 223, or 224), students will harness the color producing power of transformed bacteria to create works of living microbial art.
Linking Food Science to Biotechnology: Unlock the Color of Candies
Investigate how agarose gel electrophoresis unlocks the color code used by food scientists to make colorful candies. Students can extract colored dyes from common Valentine’s candies like Smarties Hearts and separate the dyes on agarose gel electrophoresis. To better incorporate mathematics, students will measure the distance the dyes traveled to estimate their molecular weight after running the gel. A fun lab extension involves the use of candy to build a DNA model.
An innovative way to teach the structure and function of the heart! Captivate your students with our unique model. It includes valves that open and close and can even be contracted! Students make their heart using the colorful parts working alone or in small groups. They use their model to identify the parts of the heart including the major blood vessels..
Take the arts aspect of this model one step further by printing the black and white version and let your students embellish the heart model in a way that shows how the blood flows through the heart during the cardiac cycle.

Human Heart Model
2 comments
Comments are closed.